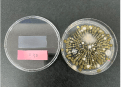

適切なカビ対策をしないと
困ったことに…
-
カビの黒ずみは
不衛生な印象カビは見た目が悪く、不快な印象を与えます。店舗やオフィスの清潔感を守るためにも適切な対策が必要です。
-
カビ胞子の
健康リスクカビの胞子を大量に吸い込むと、アレルギーや呼吸器系の不調を引き起こす可能性があります。特に敏感な方は要注意。
-
放置すれば
すぐ再発カビは菌糸を伸ばし、表面を掃除しても再発します。見えない部分まで徹底除去しないと増殖が止まりません。

ラーフエイドのカビ対策は【現場調査】【報告】を経て、
【対処】または【予防】という工法をご選択いただけます。
-
カビの徹底分析が重要
カビを除去するには、まずは現状を正しく把握することが重要です。ラーフエイドでは、以下の調査を実施し、最適な対策を提案します。

- ● 使用環境のヒアリング
- ● カビ発生の原因推定
- ● 対象面、近傍面の清浄度検査※
(定着カビ、若いカビ、古いカビをRLU値にて確認) - ● 空中浮遊菌測定(培養後にカビのコロニー数にて確認)
※ATP拭き取り検査(A3法)
カビの発生状況や胞子の浮遊状況を把握し、
効果的な対策へつなげます! -
各種測定結果に基づき
カビの状況をレポート現場調査で確認した清浄度と空中浮遊菌の測定結果からカビの状況を推察し、「真菌等測定結果報告書」として提出いたします。
さらに、以下の2つの選択肢をご提案します。- ● 【対処】カビが発生している現状を回復させる提案
- ● 【予防】再発予防対策のメンテナンス提案
状況に応じた最適な対策を、
お見積もりとともにご案内いたします。 -
徹底浸透!
カビ除去作業ラーフエイドのカビ除去作業※は、一般的な「次亜塩素酸ナトリウム」を主成分とし、独自の浸透力技術でカビの根本まで除去します。
表面だけの除去では早期再発リスクが高まりますが、ラーフエイドの除カビ剤は胞子だけでなく菌糸まで溶解除去し、長期的なカビの発生防止が期待できます。
- 〈作業の流れ〉
-
- 1. カビが定着した部分と周辺に除カビ剤を塗布
- 2. じっくり浸透させ、根本から分解・除去
- 3. 塩素臭や色落ちリスクに配慮した作業
清潔な環境を
回復させる
カビ除去技術を
お試しください!※現場調査、報告、対処は実施できない加盟店があります。あらかじめご了承ください。
防カビ維持剤で
長期カビ対策!カビの発生や再発を防ぐために、防カビ維持剤を定期的に塗布し、発生しにくい環境をつくります。
- 〈防カビ対策のポイント〉
-
- ● 古いカビによる色素沈着 → 天井材の交換&防カビ維持剤の塗布で清潔に
- ● コストを抑えたメンテナンス → 定期的な塗布でカビの再発を防止
- ● 施工タイミング → カビ除去後2週間~3ヶ月以内が効果的
- !注意事項
-
・ 防カビ試験は、SIAA指定法にて実施しています
・ 防カビ加工は、カビを死滅させるものではありません
・ 使用条件によってはカビが発生する場合があります
・ SIAAの安全性基準に適合しています
ラーフエイドの防カビ
維持剤の施工で、
清潔な空間を
長期間維持できます!

天井のカビを除去してもエアコン内部にカビが増殖していると、送風で胞子が拡散し、各所でカビが再発するリスクが高まります。
そのため、カビ除去作業を実施する際はエアコンの内部分解洗浄を推奨します。
さらに!「ラーフエイドフィルター」を併用することで
カビ除去と同時にエアコン内部を清潔に保ち、カビの再発を防ぎます。
※SIAA抗ウイルス・抗菌加工として登録されている製品です。

SIAAマークは、抗菌製品技術協議会ガイドラインで品質管理・情報公開された製品に表示されています。
- !注意事項
-
・抗ウイルス加工は、病気の治療や予防を目的とするものではありません
・SIAAの安全性基準に適合しています。

エアコンに空気洗浄機能をプラス!

室内の空気を衛生化

エアコンの風を利用して集塵した有害な細菌などをフィルターで抑制。キレイな空気を室内に循環させます。


エアコン内部を清浄に保つ

フィルターにより、汚れがつきにくくなりエアコン内部がキレイ。クリーンな送風を実現します。















